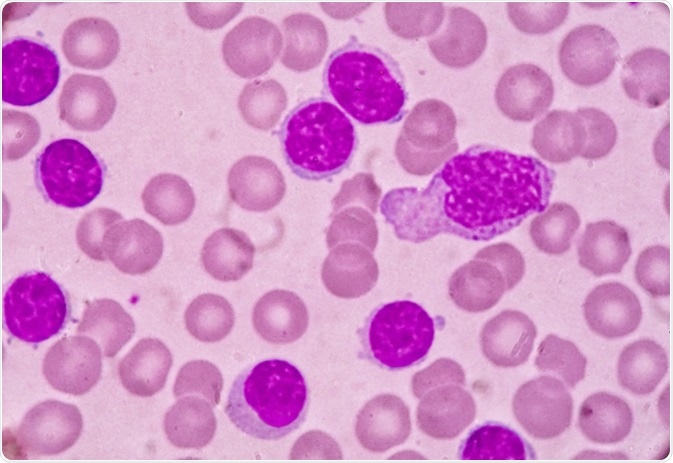
Blood smear under microscopy showing chronic lymphoblastic leukemia (CLL). Image Credit: Medtech THAI STUDIO LAB 249 / Shutterstock

By Jeyashree Sundaram (MBA)
Chronic lymphocytic leukemia (CLL) may likely arouse queries in patients about factors like prognosis and survival, both of which are based on numerous aspects.
Prognosis is a statistic taken by analyzing how far the doctor knows about the medical history of a patient, choice of treatment provided, characteristics of cancer, and stage of cancer. Estimating how an individual gets affected with cancer and his/her behavior toward the treatment are the best prognoses.
While making a prognosis, the doctor will consider the reaction of the cancer cells to treatment and the particular characteristics of the patient. Based on the reaction of cancer cells, the predicted factors are obtained. For deciding on the treatment and prognosis, the following factors play a major role.
Blood smear under microscopy showing chronic lymphoblastic leukemia (CLL). Image Credit: Medtech THAI STUDIO LAB 249 / Shutterstock
Predictive Prognostic Factors of CLL
Stage: Diagnosing cancer in an earlier stage is the most positive prognostic factor.
Age: The good outcome of prognosis among older patients is less.
Sex: Compared to women, men have a less positive prognosis.
Prolymphocytic transformation: In the blood, the presence of excessive amounts of prolymphocytes (initial stage of lymphocytes) is known as prolymphocytic transformation. In such conditions, possibilities of a favorable outcome are less.
Chromosomal changes: Possibilities of positive outcomes are greater when chromosome 13 is destroyed with no abnormal chromosomes. The outcome of prognostic factor is less when chromosome part 11 or 17 gets destroyed.
Leukemia cells in the bone marrow: The formation of different patterns by abnormal blood cells in the bone marrow depicts the presence of leukemia cells. When there is an increase in the diffused pattern, the possibilities of a favorable prognosis is less.
Levels of protein: The following protein levels mean a more favorable prognosis: the presence of beta-2-microglobulin blood level is low. Either cluster of differentiation 38(CD38) or Zeta-associated protein 70(ZAP 70) may be present in early stage CLL.
Duration of lymphocytes to multiply: The duration taken by lymphocytes to multiply is called the lymphocytes doubling time. The prognostic factor is greater when lymphocytes take 6 months to multiply.
IGHV gene mutation: The prognosis factor is more favorable when the CLL cell undergoes some changes with the gene for IGHV.
Lymphatic tissue affected region: The regions of lymphatic tissue are the spleen, lymph nodes, and liver and underarm, neck, and groin. The prognostic factor is more favorable when fewer of these areas are affected by CLL.
Performance status: Possibilities of favorable prognosis rely upon the patient's ability to perform their routine day to day work.
Richter’s syndrome: This syndrome, also termed as Richter transformation, happens when CLL intensifies into a destructive non-Hodgkin lymphoma, mainly diffuse large B-cell lymphoma (DLBCL). The probability of recovery is low when Richter's syndrome is present.
Prognosis of Chronic Lymphocytic Leukemia
Survival Statistics of CLL
Survival relies upon factors such as type of cancer, treatment options, and fitness level of an individual. It is hard to predict the span of survival as statistics are usually based on numerous groups of patients and their life experiences, which cannot help to decide the prospects of a single individual. The doctor can explain these statistics to a patient and relate them to the prognosis.
Survival by Stage
Expansive statistics of the various stages of CLL are unavailable. The below statistics of CLL are provided in the European Clinical Guidelines. It provides information about the average survival. This is the survival duration of 50% of people after diagnosis. CLL consists of three stages: A, B, and C. A is the initial stage while C is the most progressive stage.
- The average survival in stage A is about 10 years.
- The average survival in stage B is about 8 years.
- The average survival in stage C is nearly 6.5 years.
Factors Which Affect Survival
One's point of view depends upon the CLL stage and progress of the disease at the time of diagnosis. Outlook can become worse in the presence of abnormal white blood cells (lymphocytes) that are spread all over the bone marrow.
The rapid rise of the lymphocyte count can affect the outlook. Outlook also depends on sex, wherein prognosis is better in women than men. Chromosomal changes and alteration in genes can affect survival. These are determined by tests termed as cytogenetics by doctors. It becomes difficult to treat leukemia when there are certain abnormal genetic conditions in leukemia cells.
After diagnosis, the primary survival of people ranges between nearly 2 and 20 years, while the average survival is almost 10 years. No predictable and relevant test methods were available for segregating patients based on their survival and prognosis until the middle of the 1970s. Due to this reason, healing medication that relied on requirement and span was given to patients with CLL by doctors, and they were completely practical based.
The term 5-year survival is not limited to a survival of five years, but it is the survival of patients for 5 years or more after being diagnosed with CLL. A prolonged survival of more than 5 years is seen in 83% of patients.
Further Reading
Last Updated: Feb 26, 2019